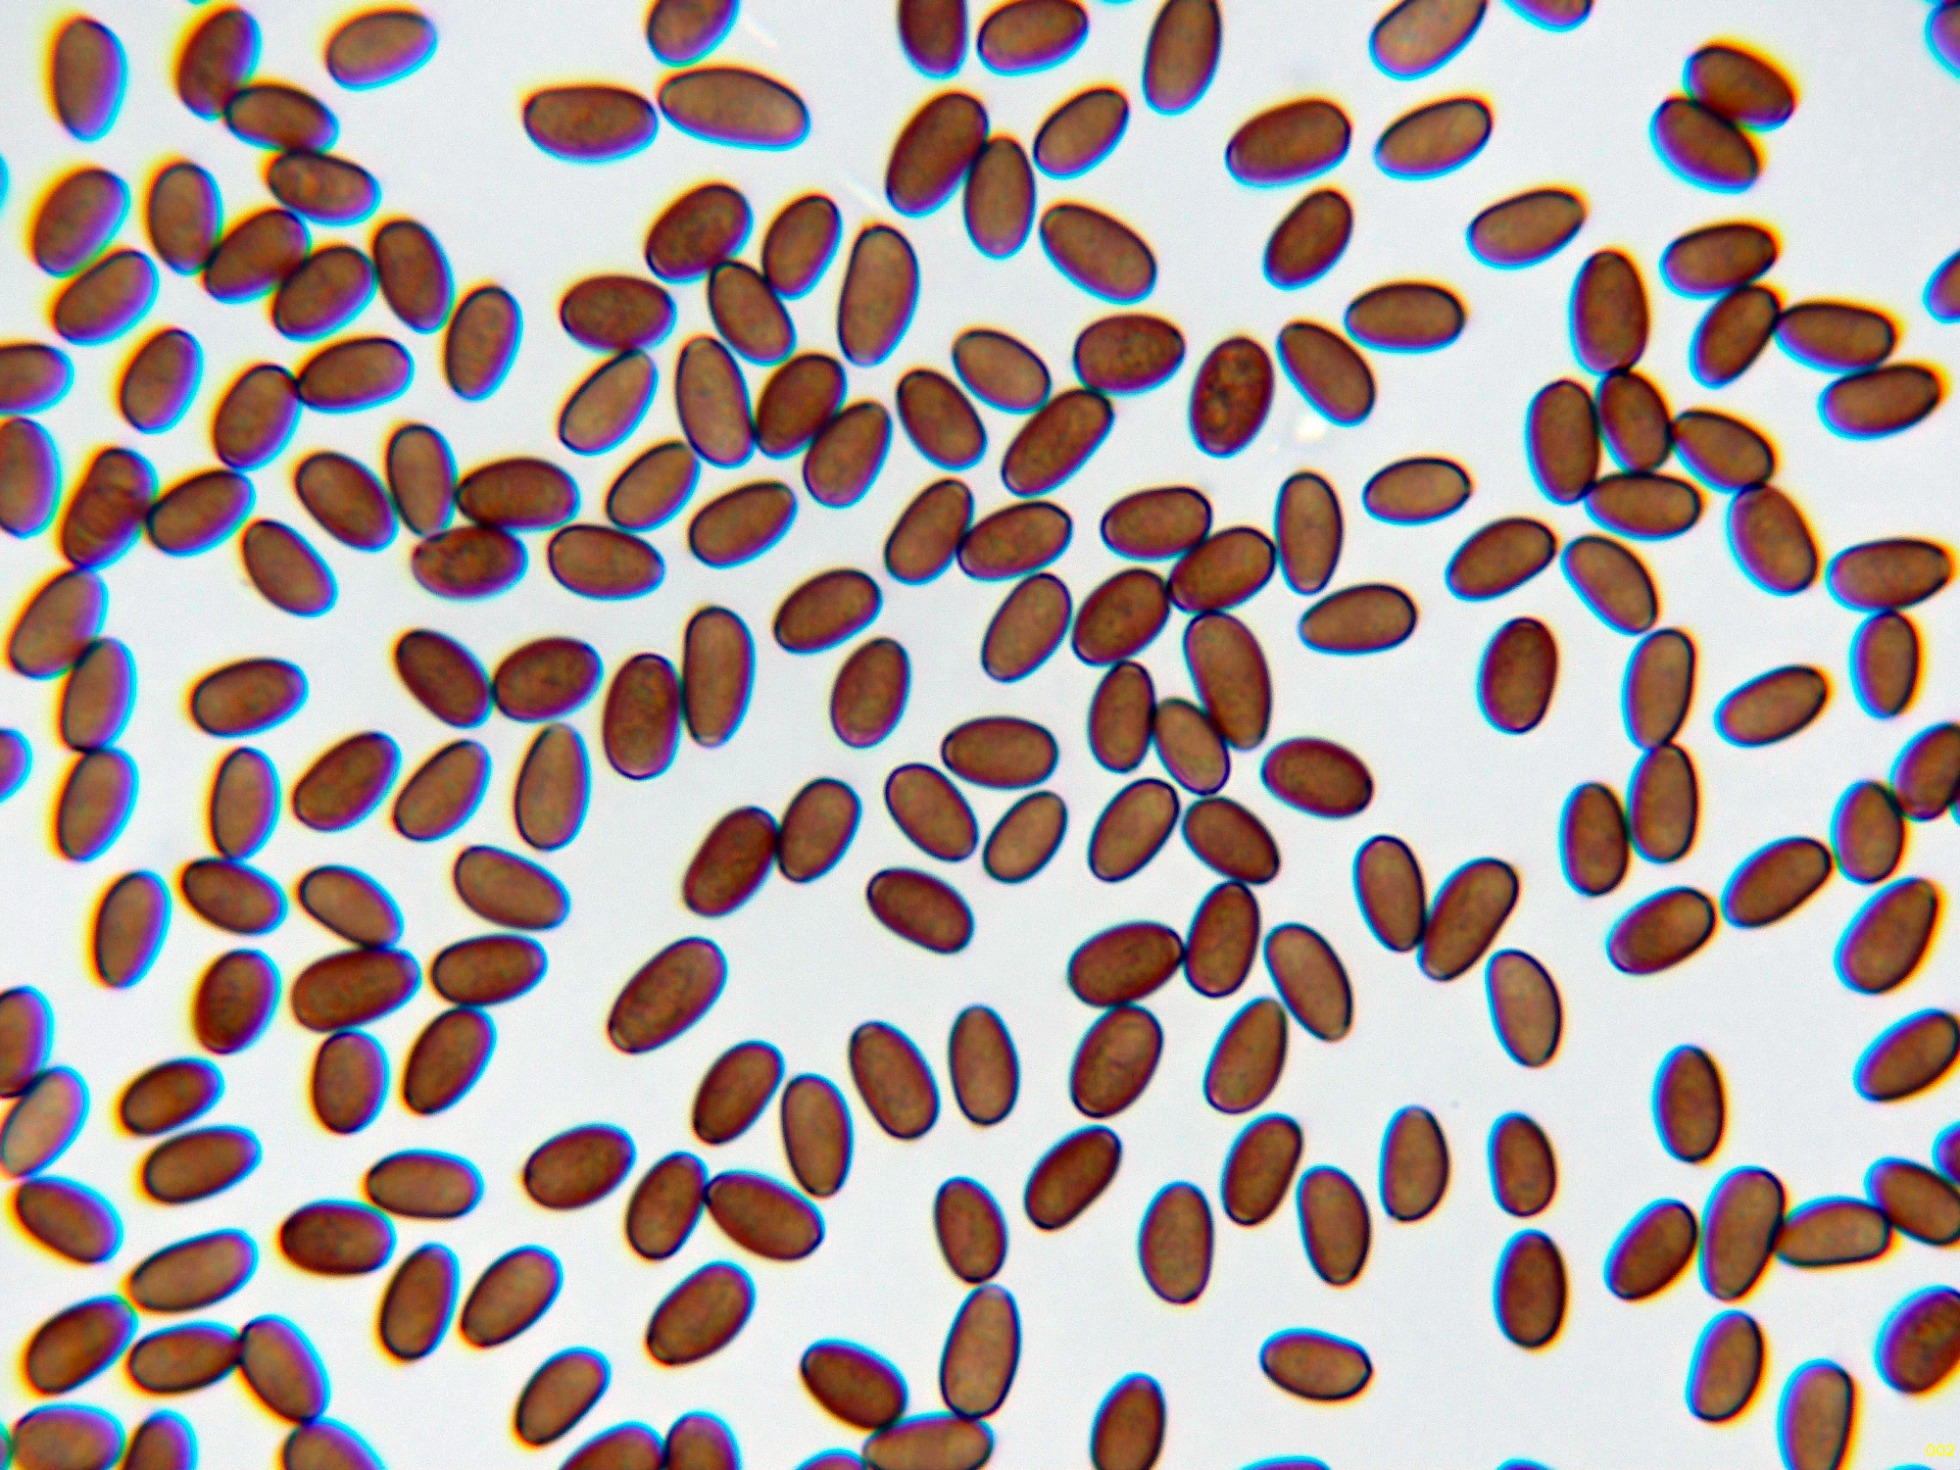

- Foro
- Foros sobre Micología de fungipedia
- Microscopía
- Media docena del 2 de junio pasado. Microscopía.
 Media docena del 2 de junio pasado. Microscopía.
Media docena del 2 de junio pasado. Microscopía.
- Josep Torres
-
 Autor del tema
Autor del tema
- Fuera de línea
- Moderador
-

Menos
Más
- Mensajes: 8746
- Gracias recibidas: 8379
1 año 9 meses antes #110027
por Josep Torres
Media docena del 2 de junio pasado. Microscopía. Publicado por Josep Torres
Hola a tod@s.
El resto de lo que dio de si la recogida de muestras del domingo 2 de junio.
El primero un Ascomiceto que solo lo había encontrado en una ocasión y precisamente en el mismo lugar, aunque esto fue allá por 2019, después de 5 años y por las mismas fechas ha vuelto a brotar, la Verpa bohemica.
Los ascos en solución de Rojo Congo a 400 aumentos.
Esporas libres en Rojo Congo a 400 aumentos.
Y unas pocas esporas obtenidas por esporulación natural y en agua.
Las esporas libres con unas medidas de:
(46.5) 52.1 - 71.2 (78) × (17) 17.6 - 21.2 (21.5) µm
Q = (2.4) 2.6 - 4 (4.3) ; N = 20
Me = 62.7 × 19.3 µm ; Qe = 3.3
Muy cerca de la anterior un Inocybe, muy probablemente la Inocybe nitidiuscula.
Hifas de la suprapellis en agua.
Caulocistidios presentes en la parte alta del pie.
Queilocistidios muy abundantes con cristalizaciones en el ápice, con unas medidas de (39.5) 47.3 - 56.8 (62.2) × (10.7) 11.4 - 15.7 (16.8) µm.
Pleurocistidios abundantes con una morfología muy parecida a los queilocistidios y con unas medidas de (52) 52.4 - 60.4 (76.4) × (14.1) 14.6 - 17.4 (18) µm.
Los basidios tetraspóricos.
Las esporas en solución de KOH, sin apenas ninguna reacción aparente.
Las esporas en agua.
En un par de mediciones a las esporas obtenidas por esporulación natural y en agua, con el resultado de:
(7.7) 8.4 - 10.1 (10.6) × (5.4) 5.6 - 6.2 (6.7) µm
Q = (1.3) 1.5 - 1.7 (1.8) ; N = 40
Me = 9.2 × 5.9 µm ; Qe = 1.6
(7.7) 8.7 - 10.3 (10.8) × (5.1) 5.4 - 6.4 (7) µm
Q = (1.4) 1.44 - 1.8 (1.9) ; N = 40
Me = 9.6 × 5.8 µm ; Qe = 1.6
Una Psathyrella que me encuentro todos los años en Primavera, la Psathyrella spadiceogrisea.
Cutícula celulósica, las hifas de la suprapellis en agua.
Los queilocistidios en Rojo Congo, estos queilocistidios con unas medidas de 38.5 - 40.7 × 11.6 - 13.2 µm.
Pleurocistidios dispersos de mayor tamaño que los queilocistidios, con unas medidas de 37.6 - 51.2 × (10.6) 10.63 - 18.2 µm.
Los basidios tetraspóricos.
Y por último las esporas obtenidas por esporulación natural y en agua.
Estas esporas con unas medidas de:
(7.4) 7.9 - 9.4 (11.1) × (4.2) 4.6 - 5.2 (5.5) µm
Q = (1.5) 1.6 - 1.9 (2.1) ; N = 40
Me = 8.5 × 4.9 µm ; Qe = 1.8
No podía faltar un Corticial, aunque este es ya la séptima vez que lo paso por el micro, la Xenasmatella vaga.
La superficie a 20 aumentos.
El himenio con los basidios.
Y una composición de las pocas esporas obtenidas por esporulación natural y en agua, tengo tan clara su identidad que ni tan siquiera me molesté en medirlas.
Y para terminar y ya sin microscopía, un par de Melanoleucas, la primera de pequeño tamaño, a la que aparece por la zona siempre la he tenido por Melanoleuca exscissa.
Y al lado de la anterior, otra Melanoleuca, esta de mayor porte, con su color característico que da lugar a su nombre, la Melanoleuca cognata.
Saludos a tod@s.
El resto de lo que dio de si la recogida de muestras del domingo 2 de junio.
El primero un Ascomiceto que solo lo había encontrado en una ocasión y precisamente en el mismo lugar, aunque esto fue allá por 2019, después de 5 años y por las mismas fechas ha vuelto a brotar, la Verpa bohemica.
Los ascos en solución de Rojo Congo a 400 aumentos.
Esporas libres en Rojo Congo a 400 aumentos.
Y unas pocas esporas obtenidas por esporulación natural y en agua.
Las esporas libres con unas medidas de:
(46.5) 52.1 - 71.2 (78) × (17) 17.6 - 21.2 (21.5) µm
Q = (2.4) 2.6 - 4 (4.3) ; N = 20
Me = 62.7 × 19.3 µm ; Qe = 3.3
Muy cerca de la anterior un Inocybe, muy probablemente la Inocybe nitidiuscula.
Hifas de la suprapellis en agua.
Caulocistidios presentes en la parte alta del pie.
Queilocistidios muy abundantes con cristalizaciones en el ápice, con unas medidas de (39.5) 47.3 - 56.8 (62.2) × (10.7) 11.4 - 15.7 (16.8) µm.
Pleurocistidios abundantes con una morfología muy parecida a los queilocistidios y con unas medidas de (52) 52.4 - 60.4 (76.4) × (14.1) 14.6 - 17.4 (18) µm.
Los basidios tetraspóricos.
Las esporas en solución de KOH, sin apenas ninguna reacción aparente.
Las esporas en agua.
En un par de mediciones a las esporas obtenidas por esporulación natural y en agua, con el resultado de:
(7.7) 8.4 - 10.1 (10.6) × (5.4) 5.6 - 6.2 (6.7) µm
Q = (1.3) 1.5 - 1.7 (1.8) ; N = 40
Me = 9.2 × 5.9 µm ; Qe = 1.6
(7.7) 8.7 - 10.3 (10.8) × (5.1) 5.4 - 6.4 (7) µm
Q = (1.4) 1.44 - 1.8 (1.9) ; N = 40
Me = 9.6 × 5.8 µm ; Qe = 1.6
Una Psathyrella que me encuentro todos los años en Primavera, la Psathyrella spadiceogrisea.
Cutícula celulósica, las hifas de la suprapellis en agua.
Los queilocistidios en Rojo Congo, estos queilocistidios con unas medidas de 38.5 - 40.7 × 11.6 - 13.2 µm.
Pleurocistidios dispersos de mayor tamaño que los queilocistidios, con unas medidas de 37.6 - 51.2 × (10.6) 10.63 - 18.2 µm.
Los basidios tetraspóricos.
Y por último las esporas obtenidas por esporulación natural y en agua.
Estas esporas con unas medidas de:
(7.4) 7.9 - 9.4 (11.1) × (4.2) 4.6 - 5.2 (5.5) µm
Q = (1.5) 1.6 - 1.9 (2.1) ; N = 40
Me = 8.5 × 4.9 µm ; Qe = 1.8
No podía faltar un Corticial, aunque este es ya la séptima vez que lo paso por el micro, la Xenasmatella vaga.
La superficie a 20 aumentos.
El himenio con los basidios.
Y una composición de las pocas esporas obtenidas por esporulación natural y en agua, tengo tan clara su identidad que ni tan siquiera me molesté en medirlas.
Y para terminar y ya sin microscopía, un par de Melanoleucas, la primera de pequeño tamaño, a la que aparece por la zona siempre la he tenido por Melanoleuca exscissa.
Y al lado de la anterior, otra Melanoleuca, esta de mayor porte, con su color característico que da lugar a su nombre, la Melanoleuca cognata.
Saludos a tod@s.
Adjuntos:
El siguiente usuario dijo gracias: Juan Andrés Román
Por favor, Identificarse para unirse a la conversación.
- Juan Andrés Román
-

- Fuera de línea
- Spammer
-

Menos
Más
- Mensajes: 2558
- Gracias recibidas: 2756
1 año 9 meses antes #110034
por Juan Andrés Román
Respuesta de Juan Andrés Román sobre el tema Media docena del 2 de junio pasado. Microscopía.
El siguiente usuario dijo gracias: Josep Torres
Por favor, Identificarse para unirse a la conversación.
- Foro
- Foros sobre Micología de fungipedia
- Microscopía
- Media docena del 2 de junio pasado. Microscopía.
Tiempo de carga de la página: 0.322 segundos

Foro de micología